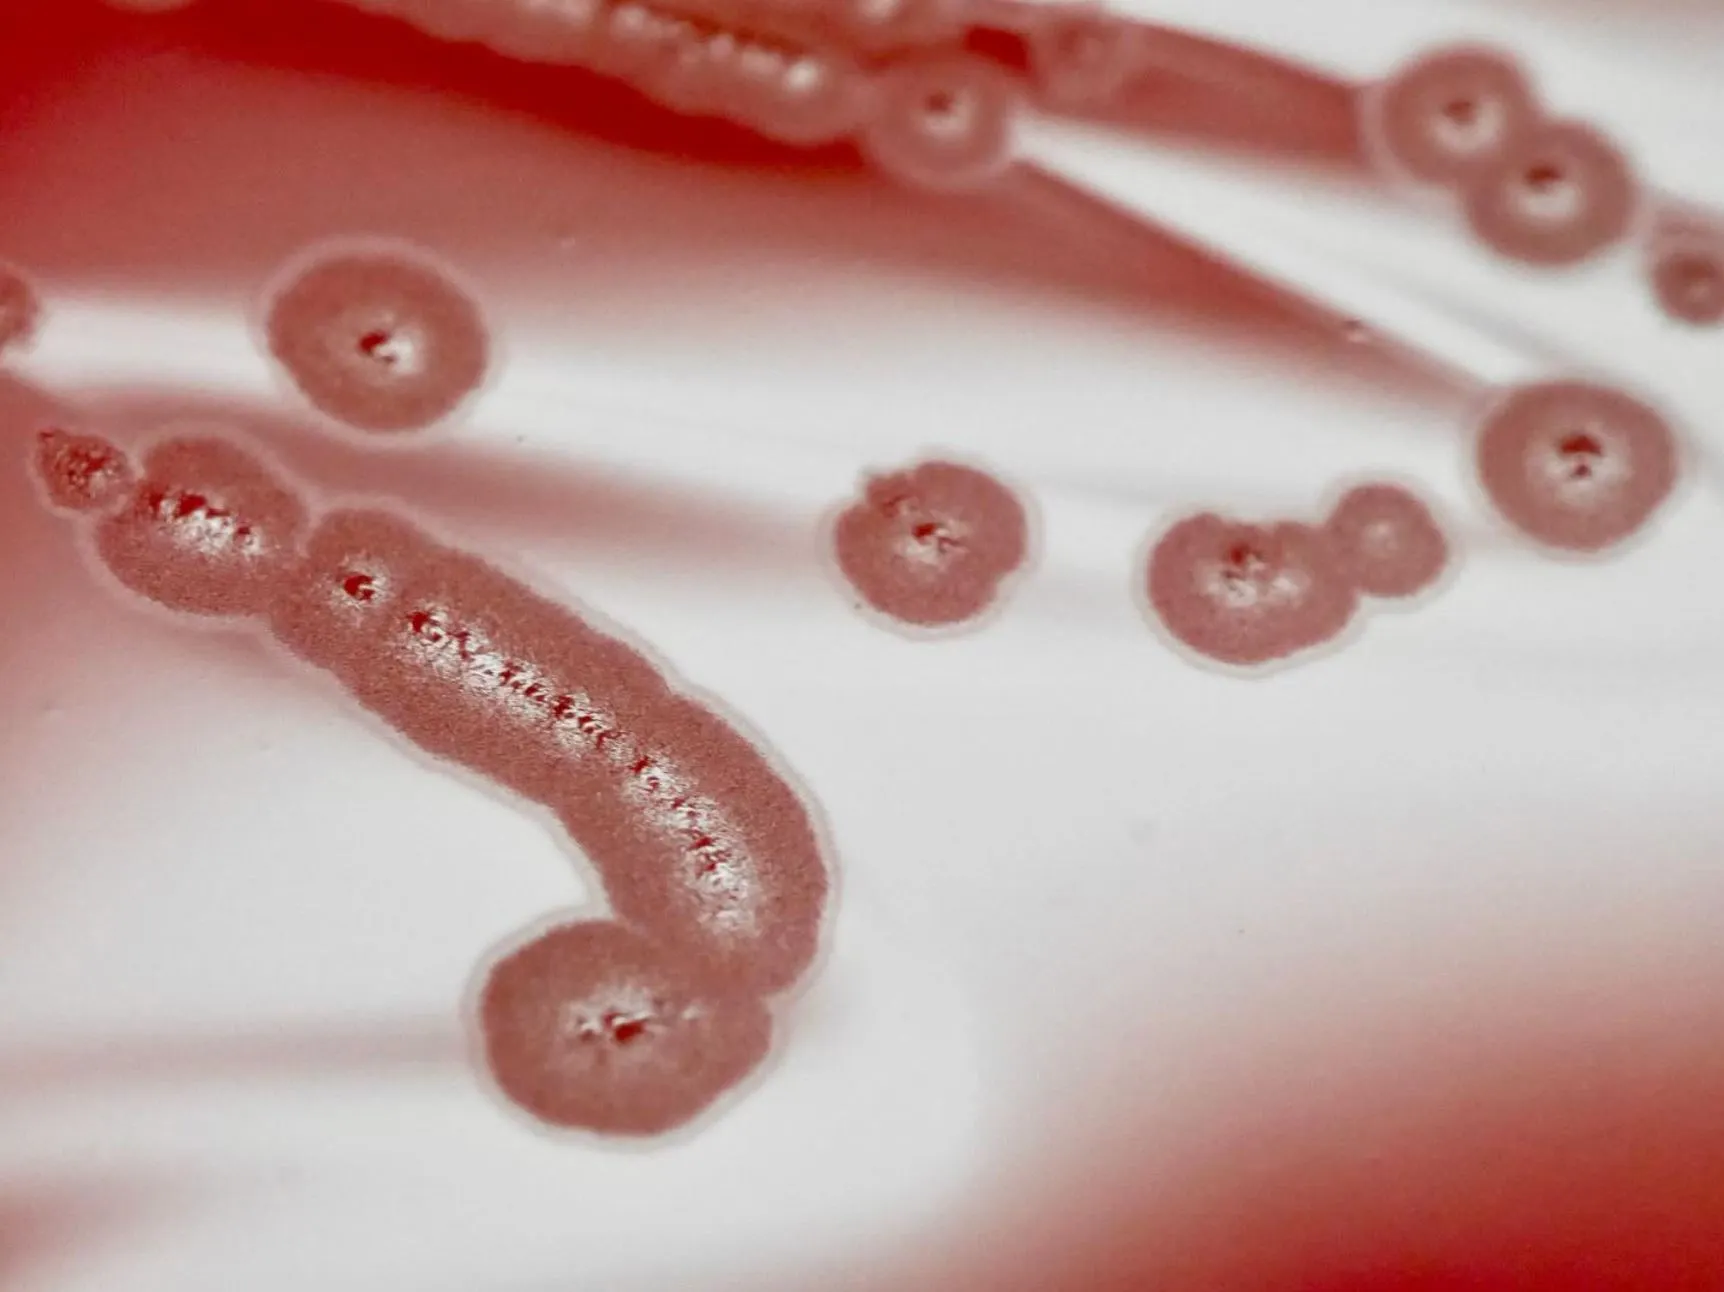

Is Bepanthen Tattoo Antiseptic? This is one of the most common Tattoo Aftercare questions clients ask as soon as their tattoo artist covers their new ink and sends them home with instructions. Fair enough — fresh tattoos are basically open wounds, and the skincare aisle can be overwhelming. With creams labelled for nappy rash, products that promise to “protect tattoos” and ointments described as dermatologically tested, how do you know which one is right for your skin?
In this guide, Uliana Kasperska — cosmetic tattooist and Brisbane studio owner — breaks down what Bepanthen actually does, whether it works as an antiseptic ointment, and how to choose the right Tattoo Aftercare Ointment for safe healing and long-term colour retention.

Table of Contents
A Closer Look at Healing Ointments
Most Australians know Bepanthen from the baby aisle, but its effective formula has made it a staple for tattoo healing too. Manufactured by a pharmaceutical giant, the Bepanthen range includes products for wound care, insect bites, and nappy rash.
The star ingredient is Pro-vitamin B5 (dexpanthenol). This compound helps boost skin recovery by improving skin barrier function and encouraging skin regeneration. It forms a breathable protective layer over the skin — often described by dermatologists as a protective layer that maintains the natural skin barrier without suffocating it.
But here’s the catch: not every Bepanthen product is designed for tattoos. Some contain added agents like antiseptic cream formulations, while others (like the Bepanthen Tattoo Aftercare Ointment) are made for gentle, daily hydration.


How Protective Ointments Help with Tattoo Healing
Here’s where confusion often kicks in:
- Bepanthen Nappy Rash Ointment and Bepanthen Tattoo Aftercare Ointment are not antiseptic. They’re designed to soothe skin and create a light, breathable layer.
- Bepanthen Antiseptic Cream is a medicated product with antimicrobial agents. It’s good for cuts, grazes or insect bites, but not for daily tattooed skin healing.
So when clients ask, “Is Bepanthen Tattoo Antiseptic?” the answer is: no, in the one most tattoo artists recommend. And that’s why it’s safe. Fresh tattoos need moisture, barrier protection and gentle cleansing with warm water and antimicrobial soap — not antiseptics that can damage the pigment.
How Tattoo Healing Works (And Why Products Matter)
A tattoo is a controlled trauma. Thousands of fine needle punctures deliver pigment into the dermis, and the body starts its natural healing process.
Healing Stage | Timeline | What You’ll See | What Helps Most |
---|---|---|---|
Inflammatory | Days 1–3 | Redness, swelling, warm skin | Gentle cleanse with lukewarm water, a thin layer of Tattoo Aftercare Ointment |
Proliferative | Days 4–10 | Scabbing, itching, peeling | Hydration, avoid scratching, keep surrounding skin moisturised |
Maturation | Days 11–30 | Settling pigment, skin looks normal | Barrier cream or Tattoo Aftercare Ointment once daily, avoid sun exposure |
Research in Wounds International and other clinical study publications shows that products with Pro-vitamin B5 and barrier protection can reduce adverse events like dryness, infection, or tattoo colour fading.
Why Antiseptic Cream Isn’t Always The Answer
It’s easy to reach for anything labelled “antiseptic” when you think of wound care supplies. But on tattooed skin, antiseptics can:
- Break down pigment, leading to uneven colour or faster tattoo colour fading.
- Disrupt the natural skin barrier, slowing the body’s skin recovery.
- Cause irritation in people with sensitive skin, leading to itching or redness.
Instead, the routine recommended by most professional tattoo artists (including us in Brisbane) is simple: wash with mild antimicrobial soap, pat dry, and apply a thin layer of Bepanthen Tattoo Intense Care Ointment or another dermatologically tested balm.
Why Bepanthen Is Popular For Tattoo Aftercare
There’s a reason so many tattooists hand clients a tube of Bepanthen:
- Gentle on sensitive skin – free from perfumes and harsh additives.
- Proven barrier protection – a waterproof protective layer that still allows skin to breathe.
- Trusted brand – Bepanthen is dermatologically tested and backed by decades of safe use.
- Affordable and accessible – available in most chemists with a clear Product code for pharmacy ordering.
Some newer tattoo balms on the market use extras like silicone gel or massage roller applicators, but the simplicity of Bepanthen still appeals to clients looking for an effective formula that supports skin hydration.
Customer Experiences And Reviews
In our studio, we hear lots of stories from clients who’ve tried different aftercare products. Many say Bepanthen feels soothing and gets them through the itchy phase, while others with oily skin sometimes prefer lighter gels after week one.
Customer reviews online reflect this too — some highlight Bepanthen’s protection formula and how “helpful staff” at pharmacies recommended it as part of their tattoo aftercare routine.
The takeaway? Like any skincare, customer experience varies, but the majority report improved comfort and visible skin regeneration with consistent use.
Statistics On Tattoo Aftercare In Australia
- 22% of Australians now have tattoos (Australian National Health Survey, 2022).
- Studies show 70% of tattoo healing complications come from poor or incorrect tattoo aftercare.
- In Brisbane’s humid climate, about 30% of aftercare issues are linked to clogged ointments or excess moisture.
- A 2023 clinical study in dermatology journals showed that dexpanthenol-based ointments improve skin barrier function and reduce irritation by 15–20%.
What To Do If You Suspect Infection
If your tattoo shows signs of infection — such as spreading redness, pus or intense heat — follow this simple guide:
- Wash gently with warm water and antimicrobial soap.
- Stop using your Tattoo Aftercare Ointment temporarily.
- Consult a GP for a professional opinion.
- Use antiseptic ointment or antiseptic cream only if prescribed.
Remember: Brisbane humidity can make tattoos look “angrier” than they are, so always check with a professional before self-diagnosing.
Final Reflection
At our Brisbane studio, we always say: keep it simple. Wash with mild soap, apply a thin layer of Bepanthen Tattoo Intense Care Ointment, and trust your body’s healing process.
Still unsure which aftercare suits your skin type? Pop by Cosmetic Tattoo Studio Brisbane Face Figurati — we’re always happy to share what works for different skin types and climates.

Using only natural and eco-friendly components for cosmetics
Special unique receipes are the secret of our spa procedures.
Experienced and skilled staff will make your perfect day
Most of our beauties come from the recommendation
FAQ
Is Bepanthen Tattoo Antiseptic?
No. The recommended ointment is not antiseptic — it’s a Tattoo Aftercare Ointment designed for hydration and barrier protection.
Can Bepanthen help prevent tattoos from fading?
Yes, keeping hydrated and a breathable barrier helps retain pigment and reduces tattoo colour fading.
Is Bepanthen Tattoo Aftercare Ointment dermatologically tested?
Yes. It’s dermatologically tested (dermatologisch getest) and safe for use on sensitive skin.
Can I use antiseptic cream instead of Bepanthen?
Not unless prescribed. Tattoo healing doesn’t need antiseptics — they can interfere with the healing process and damage pigment.
How long should I use Bepanthen after my tattoo?
Generally, 7–10 days, until the peeling stage ends. After that, switch to a light unscented moisturiser to support long-term skin hydration.